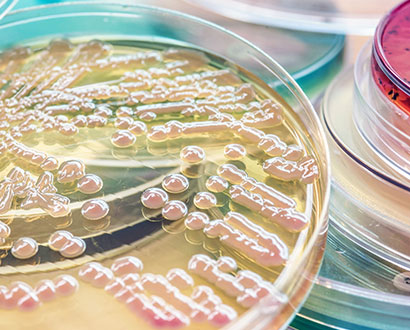

Biyoteknoloji
Homojenizasyon kullanım alanlarından en yaygını süt ve süt ürünleridir. Sütün homojenizasyonu için yüksek basınçlı homojenizatörler kullanılmaktadır.
Yüksek basınç, statik ve dinamik olmak üzere iki farklı şekilde uygulanabilir. Statik basınçta kap içerisinde hareketsiz duran sıvıya belirli bir süre yüksek basınç uygulanır. Dinamik basınçta ise sıvı yüksek basıncın etkisiyle kısa bir sürede dar bir aralıktan geçmeye zorlanır.

Biyoteknoloji

Biyoteknoloji alanında yüksek basınçlı homojenizatörler çözücü ve başka kimyasal maddelere ihtiyaç duymadan hücre içinde bulunan maddeleri çıkarmak için hücre parçalanması (hücre bozulması) yaygın olarak kullanılmaktadır.
Homojenizatör kullanılmasının temel amacı, hücre, gıda, bakteri, virüs, kan, bitki ve doku örnekleri gibi çeşitli organizmalarda yüksek konsantrasyonlarda bulunan enzimler, vitaminler ve proteinler gibi maddelerin ayrıştırılmasını sağlamaktır. Yüksek basınçlı homojenizatörler hücre parçalama işlemleri için çok etkili ve yüksek verimlidir. Elde edilen ürünlerin kalitesini çok yüksek seviyede olmaktadır.

Biyoteknoloji Ürünlerindeki Uygulama Alanları
- Bakteriler
- Enzimler
- Mayalar
- Virüsler
- Yosunlar
- Bitki Hücreleri
- Hücre Parçalamaları
- Probiyotikler
- Selülozlar
- Mikroorganizmalar
- Lipozomlar
- Algler



